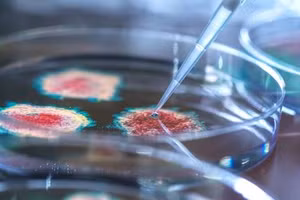
Nga lo Mỹ đang thực hiện các âm mưu gây mối họa sinh học ở Ukraine. Ảnh minh họa: RT

Bằng chứng mới về các phòng thí nghiệm sinh học 'nguy hiểm' của Ukraine
GD&TĐ - Mỹ vừa công bố bằng chứng mới cho thấy các phòng thí nghiệm sinh học do Mỹ tài trợ ở Ukraine đang nghiên cứu các mầm bệnh nguy hiểm.

GD&TĐ - Mỹ vừa công bố bằng chứng mới cho thấy các phòng thí nghiệm sinh học do Mỹ tài trợ ở Ukraine đang nghiên cứu các mầm bệnh nguy hiểm.

GD&TĐ -Quyền lực ông Trump trao cho phép Elon Musk nói thẳng về điều bí ẩn của nước Mỹ.

GD&TĐ -Trung tướng Kirillov đang nắm giữ thông tin gì khiến ông bị ám sát bởi lực lượng điệp viên Ukraine.